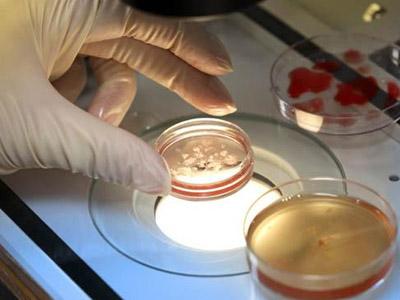
u=1342669544,1960588031&fm=27&gp=0.jpg

自1978年试管婴儿诞生以来����,该项技术就越来越受到广大的青睐�。试管婴儿行业也因此迅速发展火遍全球,其中泰国试管婴儿技术和美国试管婴儿技术更是世界��,为无数家庭送去了生育希望���。

由于泰国离中国比较近�����,而且泰国试管婴儿技术高成功率以及较低费用更是成为国内众多不孕家庭的首选�,那么泰国试管婴儿的优势到底有哪一些呢?
我们可以从以下5个方面去看泰国试管婴儿的优势:
1、第三代试管婴儿PGD技术�����,确保优生优育

有临床数据统计显示:一般人中有1/5-1/4患有遗传性疾病�����,平均每人携带4-5个隐性基因�,而高龄女性生育发生遗传性疾病的概率更高。PGD技术即胚胎移植前基因诊断�����,在移植前对胚胎进行遗传病和基因缺陷筛查���,选出健康优质的胚胎再进行移植从而降低怀孕的流产率和婴儿健康风险�。
2�����、泰国试管婴儿性价比高,费用实惠
目前世界范围内泰国和美国的试管婴儿技术发展可以说是很成熟和稳定了�����,泰国试管婴儿成功率稍低于美国试管婴儿大国��,但泰国试管婴儿却有着明显的费用优势��,只需要美国试管婴儿费用的一半����。
3�����、先进的选精受精技术����,结合优质胚胎
对于男性少精弱精者,可通过泰国第三代试管婴儿实现胚胎结合�。对于男性无精子可以通过睾丸显微穿刺取精技术在其睾丸或曲细精管中找寻优质的精子,对于艾滋�����、乙肝、丙肝�、梅毒等病毒男性携带者可通过泰国试管的洗精技术,避免遗传���,孕育健康宝宝��。
4�����、囊胚培养技术比国内要好���,胚胎成活率更高
泰国试管婴儿的胚胎培育技术行业,能将受精卵培育到第5天囊胚状态����,第5天囊胚的存活率要比第3天的胚胎高出20%。
5���、冷冻胚胎技术存活率高�����,提高植入成功率
冷冻保存技术的发展在某一层面上反映人工生殖技术的发展程度���,泰国试管婴儿采用玻璃化冷冻技术的特色就是使细胞本身及冷冻溶液在冷冻时���,呈现黏稠而不产生结晶的玻璃化状态,能使冷冻胚胎解冻存活率在大部分以上����,其植入成功率和新鲜胚胎植入成功率相当�。
较后值得一提的是,任何医疗技术都不能确保百分百成功�����,泰国试管婴儿成功率再怎么高也受诸多因素影响�����,其中个人的条件极为重要��,对试管婴儿成功率影响很大�����。另外���,试管的流程也非常关键����,任何一个步骤稍有不慎都可能影响到较终的成功率。

